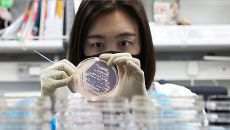

2026
일
월
화
수
목
금
토
-

양주시, GTX-C 노선 양주역 정차 경제적 타당성 확인…B/C 최대 3.98
사전타당성 조사 용역 중간보고회…저비용 고효율 사업 증명 R/C 보완 위해 복합환승센터 수익·사업비 분담 등 검토 필요 [더팩- 15시간전
- 더팩트
-

"모텔살인 피의자, 이 사람" 경찰 비공개했어도 신상 '탈탈'
경찰, 모텔 살인 피의자 신상 비공개 SNS선 신상 빠르게 확산…사적제재 논란 공개기준·결정 통일성 문제 "신상공개 기준 재검- 15시간전
- 파이낸셜뉴스
-

부산서 여야 구청장 예비후보 출마 선언 이어져
[강지원 기자(=부산)(g1_support@naver.com)] 지난 20일부터 6·3 지방선거의 기초단체장 예비후보 등록이- 15시간전
- 프레시안
-
식중독도 AI로 예방한다…"원인균 신속 발견"
식품의약품안전처는 청주오스코에서 관계부처·지자체·협회 등이 참여하는 2026년도 범정부 식중독대책협의회 고위급 회의를 개최하고- 15시간전
- 연합뉴스TV
-

제천시의회 6급 공백 18개월 '인사 지연 공방'
[중부매일 정봉길 기자] 제천시의회가 18개월째 후속 인사를 하지 않아 일부 공무원들로부터 반발을 사고 있다. 직급 결원이 있- 15시간전
- 중부매일
-

코스피 2% 급등에 국고채 금리 일제히 상승 마감(종합)
(서울=연합뉴스) 김태종 기자 = 24일 국고채 금리가 일제히 상승 마감했다. 이날 서울 채권시장에서 3년 만기 국고채 금리는- 15시간전
- 연합뉴스
-

부산교육청, 서부산권 교육 여건 개선…통학차량 지원·학교 신설
부산시교육청은 대중교통 불편 지역인 강서구 학생들을 위해 다음 달부터 부산시교육청 학생 통학버스를 제공한다고 24일 밝혔다.- 15시간전
- 쿠키뉴스
-

김동연, '달달버스' 재시동… 집중·속도·체감으로 민생 바꾼다
김동연 경기도지사가 24일 광교 경기융합타운 내 부지에서 민생경제 현장투어 출정식을 갖고 ‘달달버스’ 재시동을 걸었다. 김동연- 15시간전
- 아주경제
-

박해민 '선두타자 안타'[포토]
(엑스포츠뉴스 오키나와(일본), 고아라 기자) 24일 일본 오키나와 카데나 구장에서 열린 KIA 타이거즈와 WBC 대표팀의 연- 15시간전
- 엑스포츠뉴스
-

김동연, '달달버스' 재시동…첫 주제는 '주거복지'
[수원=뉴시스] 박상욱 기자 = 김동연 경기도지사가 24일 광교 경기융합타운 내 부지에서 민생경제 현장투어 출정식을 갖고 '달- 15시간전
- 뉴시스
-

[포토] '과학기혁신술펀드' 결성
[이데일리 김태형 기자] 배경훈(왼쪽 세번째) 부총리 겸 과학기술정보통신부 장관이 23일 여의도TP타워에서 열린 ‘과학기술혁신- 15시간전
- 이데일리
-

[ESG NOW] 기후소송, 한국 기업도 남의 일 아니다
페루의 산악 가이드 한 명이 독일 에너지 대기업을 상대로 소송을 제기했다. 황당한 이야기처럼 들릴 수 있다. 이 소송은 지금- 15시간전
- 아이뉴스24
-

중수청·공소청법 재입법예고…'검찰총장' 명칭 유지·보완수사권은 후속 과제로
[서울=뉴스핌] 김지나 박민경 기자 = 정부가 중대범죄수사청법안(중수청)·공소청법안에 대해 최초 입법예고 43일 만에 재입법예- 15시간전
- 뉴스핌
-

압수 비트코인 분실에…경찰, 위탁보관 등 관리체계 개선
(서울=연합뉴스) 이동환 기자 = 경찰이 수사 과정에서 압수한 비트코인을 보관하던 중 분실한 사건이 발생하자 관리체계 개선 방- 15시간전
- 연합뉴스
-

지상파 3사, 오픈AI 상대 소송…‘뉴스 무단 이용’ 챗GPT에 법적 책임 묻는다
글로벌 빅테크 기업 상대로 한 최초 소송 오픈AI, 상업적 운영에 적법·유효 라이선스 없이 저작권 정책 고수 협회, 韓 데이터- 15시간전
- 스포츠서울

